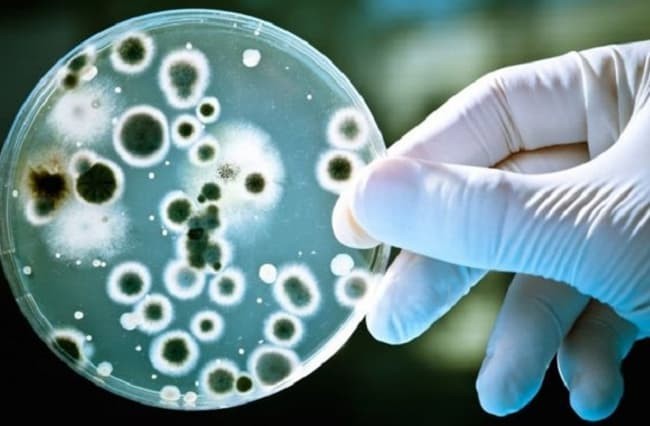
null

MỸ PHẨM CÓ LỢI CHO HỆ VI SINH – TƯƠNG LAI CỦA NGÀNH CÔNG NGHIỆP SẢN XUẤT SẢN PHẨM CHĂM SÓC DA
Loài người luôn tìm cách đấu tranh với bệnh tật. Chúng ta đã tuyên bố chiến thắng nhiều dịch bệnh, đẩy xa các giới hạn của cơ thể, tạo ra môi trường sống chúng ta cho là lành mạnh. Tuy nhiên, khi sống trong không gian sạch sẽ hơn, rửa đồ đạc và thức ăn cẩn thận hơn, thường xuyên sử dụng các chất kháng khuẩn để làm sạch cơ thể và đồ dùng, thì chúng ta lại mắc nhiều vấn đề sức khỏe và dị ứng hơn. Vậy, liệu chúng ta có đi sai hướng? Liệu sạch quá có thể làm chúng ta yếu đi?
Đã từ rất lâu, chúng ta đã biết sử dụng vi sinh vật trong cuộc sống. Nhưng chỉ mới gần đây, chúng ta có được cách nhìn khách quan và tổng thể đối với vi sinh vật. Chúng ta hiểu vi sinh vật bao gồm cả những loài có lợi và gây hại, và hiểu rằng chúng ta không thể sống tách rời với chúng. Với làn da chẳng hạn, nếu không có vi sinh vật, làn da sẽ rất mẫn cảm và dễ nhiễm bệnh.
Hiểu về Microbiome và Microbiota
Thuật ngữ dùng để chỉ các vi sinh vật sống trong và trên cơ thể người, bao gồm vi khuẩn, virus, nấm men và nấm mốc, chúng ta gọi là “hệ vi sinh” - “Microbiota”. Chúng được phân chia theo nơi ở, ví dụ Hệ vi sinh đường ruột (Gut Microbiota) là các loại vi sinh vật sống trong đường ruột, Hệ vi sinh da (Skin Microbiota) là vi sinh vật sống trên da. Thuật ngữ Microbiome đề cập đến sự nghiên cứu tổng thể bộ gene và mã di truyền của hệ vi sinh, cũng như mối liên hệ với bộ gene của người.
Vi sinh vật và con người sống cộng sinh với nhau. Mỗi bộ phận trên cơ thể người sẽ phù hợp với các loài vi sinh vật khác nhau. Các loài vi sinh vật bản địa và không gây bệnh sẽ sinh sống tại bộ phận đó, và ngăn chặn sự xâm nhập và gia tăng của những loài gây bệnh. Do đó chúng giúp bảo vệ cơ thể khỏi bệnh tật.
Nghiên cứu về Microbiome đã cho thấy mỗi người có một hệ vi sinh khác nhau về số loài và số lượng của mỗi loài. Điều này giống như việc mỗi người sở hữu một vân tay khác nhau. Tuy nhiên, hệ vi sinh của mỗi người có thể thay đổi theo trạng thái sức khỏe, môi trường sống và lối sống. Hệ vi sinh của mỗi người được hình thành từ khi sinh ra. Cách sinh nở khác nhau cũng ảnh hưởng đến hệ vi sinh của trẻ sơ sinh. Trẻ được sinh tự nhiên sở hữu nhiều Lactobacillus, Prevotella và Sneathia, trong khi trẻ sinh mổ lại có nhiều Staphylococcus, Corynebacterium và Propionibacterium từ da người mẹ. Cho con bú cũng giúp cung cấp đến 600 loài vi khuẩn và chất dinh dưỡng giúp phát triển hệ vi sinh đường ruột của trẻ sơ sinh. Dinh dưỡng cho trẻ sơ sinh ảnh hưởng đến sự phát triển, thay đổi và sự đa dạng của hệ vi sinh của trẻ, và điều này ảnh hưởng đến sức khỏe của trẻ trong tương lai.
Hệ vi sinh – Microbiota – đối với cơ thể
Lối sống, môi trường, những vật tiếp xúc, hay thực phẩm… tất cả những yếu tố này đều ảnh hưởng đến hệ sinh thái vi sinh phức tạp của mỗi người. Cùng với sự phát triển của công nghệ và y học hiện đại, liệu hệ sinh thái vi sinh trong cơ thể người có bị thay đổi?
Nghiên cứu chỉ ra rằng: những người sống ở các vùng sâu vùng xa có hệ vi sinh da phong phú (về cả số loài vi sinh và số lượng của mỗi loài) so với người sống ở đô thị. Bên cạnh đó, người có làn da yếu, da bệnh có hệ vi sinh kém đa dạng hơn người có làn da khỏe.
Công cuộc Tây hóa đã làm thay đổi cách sống của chúng ta. Chúng ta sống trong môi trường khắc nghiệt hơn. Chúng ta ăn ít rau củ quả, nhiều đạm và chất béo. Chúng ta sử dụng sản phẩm làm sạch kháng khuẩn, và thuốc kháng sinh nhiều hơn.
Lạm dụng thuốc kháng sinh khiến nhiều bệnh truyền nhiễm trở nên khó chữa trị do nguy cơ kháng thuốc. Mọi thuốc kháng sinh ngày nay đều đã có loài vi khuẩn kháng thuốc. Bên cạnh đó, thuốc kháng sinh còn có thể tác động tiêu cực đến các loài vi khuẩn có lợi đang tồn tại trong cơ thể. Chất diệt khuẩn khi sử dụng bừa bãi trên da hoặc xịt miệng có thể sinh ra nhiễm trùng do nấm hoặc do nguyên nhân khác, bởi vi khuẩn có lợi đã bị tiêu diệt và tạo điều kiện cho sự xâm lấn bởi các tác nhân ngoại lai.
Hệ vi sinh kém đa dạng trong quần thể đô thị so với những vùng hẻo lánh kèm theo tình trạng dị ứng và các bệnh tự miễn dịch ngày càng gia tăng ở đô thị có thể hỗ trợ cho giả thuyết vệ sinh: rằng sống quá sạch hoặc quá sợ vi sinh vật sẽ khiến chúng ta ít được tiếp xúc với các loài vi sinh (cả gây bệnh và không gây bệnh), từ đó khiến hệ miễn dịch trở nên kém phát triển.
Chúng ta có thể kết luận rằng lối sống ảnh hưởng đến sự đa dạng của hệ sinh thái vi sinh vật. Sạch quá không tốt đối với sự cân bằng vi sinh. Hệ miễn dịch cùng với cách chúng ta sử dụng thuốc kháng sinh ảnh hưởng rất lớn đến những loài vi sinh vật có ích trong cơ thể. Khái niệm sống hài hòa với những sinh vật nhỏ bé này là những gì chúng ta nên hướng tới.
Sự cân bằng của hệ vi sinh trên da quyết định đến số phận của làn da
Hệ vi sinh và làn da có mối quan hệ cộng sinh. Làn da là nơi sống của nhiều loại vi sinh vật. Ngược lại, chúng bảo vệ làn da khỏi những tác nhân bên ngoài, tác động vào hệ miễn dịch, tiết ra những enzyme nhằm hỗ trợ làn da và đặc biệt là hỗ trợ lớp sừng – hàng rào của da.
Mỗi vùng da chứa những loài vi sinh vật khác nhau, phụ thuộc vào các yếu tố như độ ẩm, dinh dưỡng cho vi sinh vật, độ pH. Hệ vi sinh của mỗi người là khác biệt, kể cả khi xét cùng một vùng da như bàn tay, hoặc trên lưng.
Mặc dù hệ vi sinh của mỗi người một khác, nhưng người có vấn đề da như viêm da dị ứng, vẩy nến, hoặc mụn thì có hệ vi sinh kém đa dạng và ít về số lượng của từng loài vi sinh vật. Đặc biệt với những làn da tổn thương da nghiêm trọng, sự đa dạng vi sinh còn kém hơn nữa và những loài vi sinh vật gây bệnh xuất hiện cao hơn.
Quá trình tiếp cận với dữ liệu di truyền của hệ vi sinh cũng làm thay đổi nhận thức về mối quan hệ giữa các loài vi si vinh vật. Ngày trước, chúng ta cho rằng P.acne là nguyên nhân gây mụn. Tuy nghiên, những nghiên cứu gần đây cho thấy giữa người không mụn và người có mụn có số lượng P.acne tương tự nhau, nhưng người mụn có một số loài P.acne có số lượng nhiều hơn và một số khác ít hơn. Như vậy chúng ta có thể kết luận rằng P.acne không phải tác nhân chính gây mụn, mà mất cân bằng giữa các loài P.acne mới có thể là nguyên nhân gây mụn.
Chúng ta cũng phát hiện rằng tình trạng viêm da hoặc mụn có thể liên quan đến những loài vi sinh vật khác như Staphylococcus aureus, loài này kích hoạt quá trình viêm thông qua TLR-2. Bệnh nhân nhiễm tình trạng này có số lượng S.aureus ở vùng tổn thương cao hơn, khiến mất cân bằng vi sinh. Tái cân bằng vi sinh như vậy là một cách thức để điều trị cho vấn đề này.
Tuy nhiên, vẫn còn rất sớm để khẳng định loài vi sinh nào là có lợi hay có hại. Hiện tại chưa có tiêu chuẩn quốc tế nào về thu thập, xử lý và phân tích các mẫu vật để so sánh các hệ vi sinh. Mẫu vật nếu bị nhiễm khuẩn cũng sẽ gây ra trở ngại cho việc kết luận chính xác. Vì thế, chúng ta cần thêm thông tin để hiểu hơn về mối quan hệ phức tạp của hệ sinh thái này.
Hệ vi sinh trên da và mỹ phẩm
Sự đa dạng và cân bằng vi sinh là những chỉ số để đánh giá làn da. Môi trường sống ảnh hưởng trực tiếp đến hệ vi sinh trên da. Mỹ phẩm chăm sóc da cùng với việc lau, rửa, chà xát, thoa kem… đều ảnh hưởng đến hệ vi sinh, có thể theo cách tích cực hoặc tiêu cực. Các loại nguyên liệu cũng tương tự, có thể có lợi hoặc bất lợi với hệ vi sinh.
Kiến thức về sự cân bằng vi sinh dẫn đến một kỷ nguyên mới cho mỹ phẩm. Có nhiều hội nghị chuyên ngành, xuất hiện những thành phần liên quan đến hệ vi sinh trong vài năm trở lại. Người tiêu dùng trên thế giới bắt đầu ý thức hơn, và nhiều nhãn hàng đã tung ra sản phẩm ra thị trường theo chủ đề này. Ở Thái Lan, đã có nhiều thảo luận giữa những người trong ngành và những chuyên gia y tế, nhưng vẫn còn ít những trao đổi tương tự ở phía người tiêu dùng.
Mỹ phẩm dưỡng da: Probiotics và Prebiotics
Trên thế giới hiện có nhiều sản phẩm mỹ phẩm với tuyên bố “Probiotic Skincare”, có nghĩa là sản phẩm hứa hẹn điều chỉnh và làm cân bằng hệ vi sinh trên làn da, hứa hẹn khắc phục mụn và các vấn đề da khác. Những sản phẩm này có thể chứa những thành phần lên men từ vi sinh vật (men hoặc vi khuẩn). Chúng ta không biết chắc chắn những sản phẩm này sẽ ảnh hưởng thế nào đến hệ vi sinh da, do đó cách các nhãn hàng tự gọi sản phẩm của mình là “Probiotic skincare” có thể gây hiểu lầm. Bởi mỹ phẩm “Probiotics” chỉ thực sự đúng nếu sản phẩm đó đưa được vi khuẩn sống đến làn da cũng như vi khuẩn đó phải sống sót và phát triển trên làn da (giống trường hợp ăn sữa chua, sữa lên men và kimchi – vi khuẩn vẫn sống mới có thể hỗ trợ đường ruột). Chúng ta phải nhớ rằng theo luật, mỹ phẩm phải đáp ứng nhu cầu về vi sinh vật. Và chúng ta cũng không muốn mỹ phẩm chứa bất cứ sinh vật gây hại nào bởi sinh vật đó có thể gây bệnh.
Vì những lý do này, tác giả cho rằng không có mỹ phẩm probiotic nào trong ngành công nghiệp mỹ phẩm hiện tại. Không có vi sinh vật sống và nguyên vẹn nào được cố ý đưa vào mỹ phẩm. Liệu mỹ phẩm probiotics có lợi cho làn da? Có thể có, vì một số chiết xuất từ men, vi khuẩn hoặc một số chất lên men là có ích. Tuy các nhà khoa học có thể thực sự đưa vi sinh vật vào mỹ phẩm (ví dụ vi sinh vật khô/ngủ đông, ở dạng bột và sẽ pha với nước để thoa lên mặt), điều này vẫn không có vẻ là một ý tưởng tốt bởi mỗi người có một hệ vi sinh khác nhau. Làm thế nào để các nhà khoa học chắc chắn rằng sản phẩm đó phù hợp với người nào? Khi người tiêu dùng có một vết thương hở, mỹ phẩm đó có an toàn hay không?
Một khả năng tuyên bố mỹ phẩm chăm sóc da là hỗ trợ hệ vi sinh chấp nhận được là khi đưa nguyên liệu hoặc sản phẩm hỗ trợ cho sự đa dạng và cân bằng hệ vi sinh da. Khái niệm này gọi là “Prebiotics”. Nguyên tắc của “Prebiotics” là cung cấp dinh dưỡng để phát triển hệ vi sinh. Dinh dưỡng có thể là các nguyên liệu, ví dụ khoáng chất, chiết xuất, protein, peptide.
Chúng ta có thể kết luận từ những điều trên, rằng, hệ sinh thái tí hon của cơ thể và trên làn da là rất quan trọng. Chúng giúp cơ thể hoạt động và khỏe mạnh. Lối sống hiện đại đang khiếm khuyết nhận thức về cân bằng vi sinh, từ đó sinh ra nhiều vấn đề sức khỏe. Chúng ta phải thay đổi nhận thức và học cách sống hài hòa với hệ vi sinh của mình, bắt đầu từ việc tìm cách cân bằng vi sinh. Sống quá sạch có thể hủy hoại sự cân bằng và làm yếu hệ miễn dịch. Tất nhiên chúng ta không thể thay đổi lối sống trong một sớm một chiều hay là kỳ vọng cơ thể cải thiện ngay sau một hôm. Hệ miễn dịch cần thời gian để điều chỉnh.
Đối với việc chăm sóc da, không phải lúc nào cũng sử dụng chất tẩy rửa có khả năng kháng khuẩn bởi những sản phẩm này không khác so với sử dụng các sản phẩm tẩy rửa thông thường.
Khi biết điều này, hãy chăm sóc tốt cho hệ vi sinh của bạn.
(Theo Innolab)
Đọc tiếp cùng chuyên mục
Điều trị da sau khi dùng kem trộn chứa corticoid
Mỹ phẩm - 18/05/2021
Do thiếu kinh nghiệm, ham rẻ, lại muốn làn da đẹp nhanh chóng nên nhiều chị em đã trở thành nạn nhân của kem trộn. Làn da không những không đẹp mà còn...